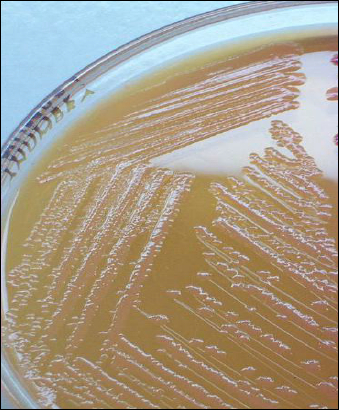
image 19
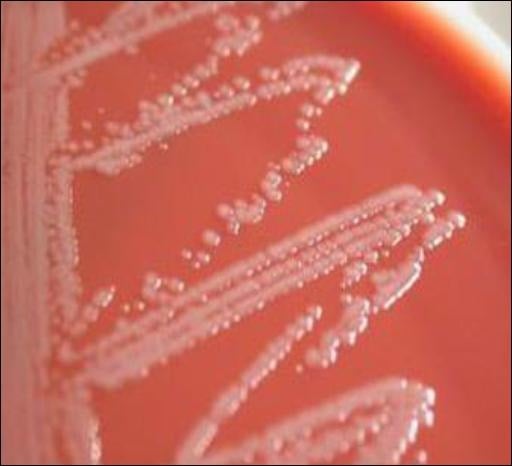
image 10

Acinetobacter baumannii is a highly adaptive, opportunistic pathogen that greatly affects immunocompromised individuals. Due to their multidrug resistance and their significant role in nosocomial (hospital-acquired) infections, they are also recognized as one of the ESKAPE pathogens.

The genus Acinetobacter was first isolated from soil by the Dutch microbiologist Martinus Willem Beijerinck in 1911, who named it Micrococcus calcoacetius. Later in 1954, Brisou and Prevot named the organism Acinetobacter, separating the non-motile species from motile members of the genus Achromobacter. In 1970, Acinetobacter baumannii was identified as a separate species and named in honor of Paul Baumann.
Taxonomy and Classification of Acinetobacter baumannii
The taxonomy of Acinetobacter baumannii:
| Domain | Bacteria |
| Phylum | Proteobacteria |
| Class | Gammaproteobacteria |
| Order | Pseudomonadales |
| Family | Moraxellaceae |
| Genus | Acinetobacter |
| Species | baumannii |
Morphology and Microscopy of Acinetobacter baumannii
Acinetobacter baumannii is a Gram-negative, aerobic pleomorphic coccobacillus.
- Shape: Short rod or coccobacillus
- Dimension: 0.9-1.6𝜇m in width and 1.5-2.5𝜇m in length
- Gram reaction: Gram-negative
- Arrangement: Occurs singly, in pairs or short chains
- Spore: Non-spore-forming
- Motility: Non-motile (lacks flagella)
Acinetobacter baumannii are non-motile as they lack flagella, but exhibit motility by swarming or twitching with the help of Type IV pili. They are non-fermenting, non-fastidious bacteria. Under microscopy, the bacterial cell appears as a small, pink coccobacilli.

https://pbs.twimg.com/media/EQlUAHOXYAQ6aEF.jpg
Cultural and Growth Characteristics of Acinetobacter baumannii
Acinetobacter baumannii is strictly aerobic, but can also survive in different oxygen environments, including no oxygen. Most strains of this bacterium can grow well at temperatures ranging from 20℃ to 44℃ and a pH between 6.0 and 7.0. However, the optimal temperature is 37℃. Some environmental isolates can survive at 4℃ (psychrophilic) or up to 48℃ (thermophilic).
- Nutrient Agar: The colonies on nutrient agar appear to be smooth, pale yellow to green colored, and are about 1-2mm in diameter.
- MacConkey Agar: As A. baumannii are non-lactose fermenters, the colonies on MacConkey agar appear small, shiny and translucent, measuring 2-3mm in size.
- Blood Agar: The colonies on blood agar appear as opaque, smooth, convex and white with no hemolysis around the colonies. They are non-hemolytic.
- CHROMagar Acinetobacter: This is the selective agar for the identification of Acinetobacter baumannii. The colonies on this agar, after overnight incubation, appear to be conspicuous red.
- CLED Agar: The colonies on CLED media appear to be pale and translucent since the colonies are non-lactose fermenting.
http://www.medical-labs.net/wp-content
uploads/2014/04/Acinetobacter-on-
MacConkey-Agar-non-lactose-fermenting.jpg

CHROMagar™ Acinetobacter – Chromagar
http://www.medical-labs.net/wp-content
/uploads/2014/04/Acinetobacter2.jpg
Biochemical and Identification Test of Acinetobacter baumannii
- Basic Characteristics
| S.N | Biochemical Characteristics | Acinetobacter baumannii |
| 1. | Oxidase | Negative |
| 2. | Catalase | Positive |
| 3. | Urease | Negative |
| 4. | Citrate | Positive |
| 5. | MR (Methyl-Red) | Negative |
| 6. | VP (Voges-Proskauer) | Negative |
| 7. | Indole | Negative |
| 8. | H2S | Negative |
| 9. | Coagulase | Negative |
| 10. | Nitrate Reduction | Negative |
| 11. | Gelatin Hydrolysis | Negative |
| 12, | OF (Oxidative-Fermentative) | Non-Fermentation (Oxidative) |
- Fermentation
| 1. | Galactose | Positive |
| 2. | Glucose | Positive |
| 3. | Lactose | Negative |
| 4. | Sucrose | Negative |
| 5. | Xylose | Positive |
| 6. | Maltose | Variable |
- Enzymatic Reactions
| 1. | Beta Lactamase | Positive |
| 2. | Lipase | Positive |
| 3. | Histidine | Positive |
| 4. | Histamine | Negative |
| 5. | Lysine | Variable |
| 6. | Malate | Positive |
Virulence Factors and Pathogenesis of Acinetobacter baumannii
The virulence of bacterium Acinetobacter baumannii is determined by factors that enhance survival, colonization and immune evasion.
- Biofilm formation: A. baumannii strains have the ability to form biofilms on both abiotic (inanimate surfaces) and biotic surfaces (host tissue). This biofilm formation protects the bacteria from antibiotics, antiseptics, and the host’s immune system, allowing it to grow in hospital environments and increasing the risk of nosocomial outbreaks.
- Outer Membrane Proteins (OMPs): OMPs are involved in tissue damage and immune evasion. OMPs, such as OMP-A, attach to epithelial cells and play a role in the formation of biofilms.
- Lipopolysaccharides (LPS): Lipopolysaccharides enhance serum resistance, support survival in host tissue infection, and help in evasion of host immune response. LPS protects the bacterium from environmental stress, disinfectants and desiccation. The lipid A portion of LPS acts as an endotoxin activating TLR4 (Toll-like receptor 4) on host immune cells. Excessive TLR4 activation can cause septic shock or sepsis. Lipid A modification also protects the bacterium from antimicrobial peptides, increasing its survival.
- Capsules: The capsules of polysaccharides play a central role in immune evasion and prevent phagocytosis. It protects the bacterium against complement-mediated killing.
- Nutrient Acquisition: A. baumannii utilizes specialized mechanisms to obtain iron in the iron-deficient environment of the host. It synthesizes siderophores and employs hemolytic activities to extract iron from host cells, which provides nutrients for bacterial growth, increasing the ability to cause disease.
- Outer Membrane Vesicles (OMVs): A. baumannii produces outer membrane vesicles (OMVs) that contain proteases, catalase, phospholipids and superoxide dismutase. These components play a role in tissue damage, biofilm formation and immune response modulation.
- Motility: The bacterium shows twitching motility using type IV pili and synthesizes 1,3-diaminopropane, which helps in spreading on the surfaces and colonizing new sites.
- Biofilm formation: A. baumannii strains have the ability to form biofilms on both abiotic (inanimate surfaces) and biotic surfaces (host tissue). This biofilm formation protects the bacteria from antibiotics, antiseptics, and the host’s immune system, allowing it to grow in hospital environments and increasing the risk of nosocomial outbreaks.
- Immune Evasion: Capsules, biofilm, LPS, Lipid A modifications, OMPs help the bacteria evade immune response.

https://www.researchgate.net/publication/339888158/figure/fig2/AS:11431281332971776@1743265715550/An-illustration-of-virulence-determinants-possessed-by-Acinetobacter-baumannii-The.tif
Epidemiology and Transmission of Acinetobacter baumannii
Acinetobacter baumannii is a leading opportunistic pathogen worldwide, especially in tertiary care hospitals and health care sites. Globally spread strains, especially Global Clones 1 and 2, carry important carbapenem- resistance genes and are found across various continents. Notably, in areas like Europe, Asia, and the United States, there has been a massive increase in carbapenem- resistant A. baumannii (CRAB) in the past few years. This bacterium mainly affects patients who are critically ill, immunocompromised individuals, burn and trauma patients, ventilator patients, and patients with prolonged hospital stays.
As A. baumannii can grow and survive on abiotic surfaces, it generally transmits through environmental contamination. They are resistant to disinfectants, so they survive on surfaces like bed rails, medical devices, hospital furniture and door handles. It is commonly spread through the hands of healthcare staff when proper hand hygiene is not followed. In critically ill patients, the skin and oral cavity can become colonized and serve as a source of infection, eventually leading to bloodstream infection or pneumonia.
Clinical Manifestation of Acinetobacter baumannii
Acinetobacter baumannii is an opportunistic pathogen associated with various diseases, each infection presenting distinct symptoms. It is commonly associated with intensive care units (ICU), mechanical ventilation, and prolonged hospital stays. Some of the sites of infection and their symptoms are:
- Hospital-acquired pneumonia: Fever, cough, sputum purulence (yellow, bloody mucus), breathing problem, muscles and chest pain.
- Meningitis: Headache, neck stiffness, altered consciousness, fever
- Bloodstream infections: Chills, high fever, hypotension, altered mental status, septic shock, multi-organ dysfunction
- Urinary tract infection: Painful or burning urination, fever, suprapubic pain, and pyuria.
- Wound infections: Swelling, purulent discharge, delayed wound healing, tissue necrosis.
- Skin and soft tissue infections: Skin break, cellulitis.
Laboratory Diagnosis of Acinetobacter baumannii
Several methods are used for the isolation and identification of A. baumannii, such as microscopy, culture, and biochemical tests.
- Sample collection: Clinical specimens are collected from different sites of infection, such as blood, urine, sputum, wound swabs, pus, and tracheal aspirates for the diagnosis of A. baumannii.
- Gram Stain: Gram staining is performed using Gram’s iodine to differentiate the bacteria.
- Culture: The collected samples are cultured in Nutrient agar, MacConkey agar, Blood agar, CHROMagar, and CLED agar, respectively. The agar plates are then incubated at 37℃ for 24 hours.
- Biochemical tests: Various biochemical tests, such as oxidase, catalase, citrate, motility, urease, and oxidative-fermentative (O/F), are performed after the formation of colonies.
- Molecular Methods: Molecular methods like PCR (polymerase chain reaction) are used for detecting MDR strains and the carbapenem resistance gene of A. baumannii. Another method is whole genome sequencing.
- Automated Identification: Rapid and accurate identification of the species is done by automated identifications like VITEK and MALDI-TOS mass spectrometry.
- Antibiotic susceptibility test: AST is performed by the Kirby-Bauer disk diffusion method. This helps to determine the resistance pattern of the bacterium.
Treatments for Acinetobacter baumannii
As Acinetobacter baumannii is a multidrug-resistant bacterium, treatment of this infection is challenging. Treatment usually depends on Antibiotic Therapy.
- Antibiotic Therapy: Previously, antibiotics like imipenem and meropenem were the choice for the treatment, but the rate of carbapenem resistance has gradually increased. So, drugs like Colistin (polymyxin E) are used for carbapenem-resistant strains. Colistin may cause neurotoxicity, so this drug alone is considered a last resort antibiotic. Antibiotics like Cefiderocol (also known as the newer “siderophore-cephalosporin”) lower the death rate and improve the cure rate. A new β-lactam / β-lactamase inhibitor Sulbactam-durlobactam is an effective antibiotic for carbapenem-resistant infection that comparably causes less renal toxicity than Colistin.
- Combination Therapy: For several infections like hospital-associated pneumonia and sepsis, combination therapy is recommended. Polymyxin-based combination like Colistin +Carbapenem, Colistin+Tigecycline, Colistin+Sulbactam or fosfomycin is recommended. For carbapenem-resistant Acinetobacter baumanni (CRAB), high-dose Ampicillin-Sulbactam combined with Meropenem, Tigecycline is also recommended.
Antimicrobial Resistance of Acinetobacter baumannii
Acinetobacter baumannii has emerged as one of the most resistant bacteria in the hospital setting, complicating the treatment of infection. Due to the combination of intrinsic characteristics and acquired resistance strategies, it has the capacity to resist antibiotics.
- Intrinsic Traits: Due to the distinct cell wall structure and active efflux pumps that remove medicine from bacterial cells, antibiotics, like ampicillin, aztreonam and amoxicillin, are inefficient against A. baumannii.
- Acquired Resistance Mechanisms: Mechanisms like β-lactamase production, Lipid A modification, Biofilm production and Efflux pumps help the bacteria to acquire resistance.
- β-lactamase production: A. baumannii produces enzymes like β-lactamase that destroy penicillin and carbapenems.
- Target site alteration: Susceptibility to Fluoroquinolone and colistin is reduced by mutation in DNA gyrase/topoisomerase or lipid A biosynthesis.
- Porin Modification: Changes in the outer membrane proteins inhibit antibiotics from entering the bacteria.
- Biofilm production: As the bacteria have the ability to produce biofilms, they are protected from antibiotics and the immune system.
Prevention and Control of Acinetobacter baumannii
As Acinetobacter baumannii are nosocomial pathogens, prevention of this bacterial infection involves strict control measures, especially in hospital settings. A. baumannii infections can be prevented and controlled by:
- Hygiene: Strict hand hygiene should be enforced among healthcare workers, patients and visitors. Use of alcohol-based hand rub and proper hand washing with soap and water.
- Personal Protective Equipment (PPE): Use of gowns, masks and gloves when meeting an infected person or handling contaminated surfaces. To prevent cross-contamination, proper disposal of PPE is necessary.
- Environmental cleaning: Regular disinfection of the hospital surface areas and medical equipment should be done
- Device Management: Medical devices like ventilators and catheters should be removed as early as possible when no longer needed. They should be sterilized properly before use.
- Surveillance: Routine cultures on the high-risk admission should be performed, and the patient should be isolated properly. Infection tracking systems should be implemented in hospitals.
- Education and training: Hospital staff should be provided with regular training on infection control protocols.
Conclusion
Acinetobacter baumannii is a nosocomial pathogen that has been a leading cause of multidrug-resistant infections worldwide. The ability to produce biofilm, survive in hospital environments, develop resistance mechanisms, and evade host immune defense has made this infection hard to manage and treat. Effective management of this infection depends not only on antibiotic therapy but also on strict infection control practices. Hand hygiene, use of personal protective equipment (PPE), medical device management and surveillance by the healthcare staff help reduce the transfer of this infection in hospital settings.
Reference
- Lee, C. R., Lee, J. H., Park, M., Park, K. S., Bae, I. K., Kim, Y. B., Cha, C. J., Jeong, B. C., & Lee, S. H. (2017). Biology of Acinetobacter baumannii: Pathogenesis, Antibiotic Resistance Mechanisms, and Prospective Treatment Options. Frontiers in cellular and infection microbiology, 7, 55. https://doi.org/10.3389/fcimb.2017.00055
- Espinal, P., Martin, S., & Vila, J. (2012). Effect of biofilm formation on the survival of Acinetobacter baumannii on dry surfaces. The Journal of Hospital Infection. https://doi.org/10.1016/j.jhin.2011.08.013
- Ibrahim, S., Al-Saryi, N., Al-Kadmy, I. M.S., & Aziz, S. N. (2021). Multidrug-resistant Acinetobacter baumannii as an emerging concern in hospitals. https://doi.org/10.1007/s11033-021-06690-6
- Li, S., Jiang, G., Wang, S., Wang, M., Wu, Y., Zhang, J., Liu, X., Zhong, L., Zhou, M., Xie, S., Ren, Y., He, P., Lou, Y., Li, H., Du, J., & Zhou, Z. (2025). Emergence and global spread of a dominant multidrug-resistant clade within Acinetobacter baumannii. Nature communications, 16(1), 2787. https://doi.org/10.1038/s41467-025-58106-9
- Lodise, T. P., Nguyen, S. T., Margiotta, C., & Cai, B. (2025). Clinical burden of Acinetobacter baumannii, including carbapenem-resistant A. baumannii, in hospitalized adult patients in the USA between 2018 and 2022. BMC infectious diseases, 25(1), 549. https://doi.org/10.1186/s12879-025-10749-1
- Müller, C., Reuter, S., Wille, J., Xanthopoulou, K., Stefanik, D., Grundmann, H., Higgins, P. G., & Seifert, H. (2023). A global view on carbapenem-resistant Acinetobacter baumannii. mBio, 14(6), e0226023. https://doi.org/10.1128/mbio.02260-23
- Peleng, A. Y., Seifert, H., & Paterson, D. L. (2008, July 1). Acinetobacter baumannii: Emergence of a Successful Pathogen. Clinical Microbiology Review. https://doi.org/10.1128/cmr.00058-07
- Stanley, C. N., Awanye, A. M., & Ogbonnaya, U. C. (2023). Acinetobacter baumannii: Epidemiology, Clinical Manifestations and Associated Infections. Acinetobacter baumannii- The Rise of a Resistant Pathogen. https://doi.org/10.5772/intechopen.1003618